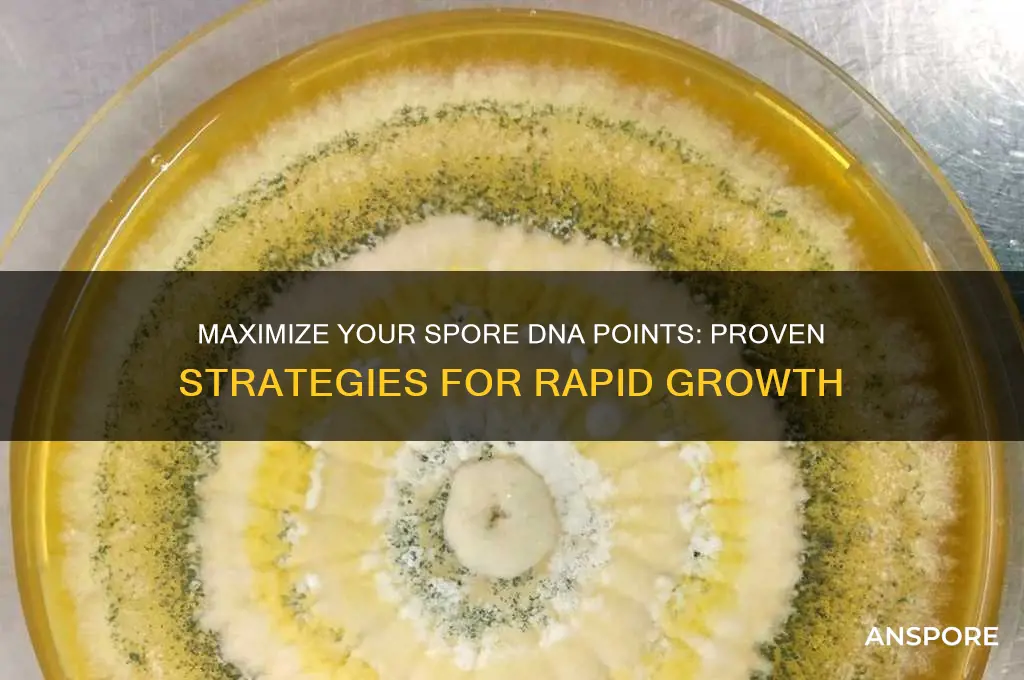
how to get more dna points in spore

In *Spore*, DNA points are essential for unlocking new parts and advancing your creature's evolution, allowing you to create more complex and specialized organisms. To maximize your DNA points, focus on completing key objectives in each stage, such as socializing with other creatures, hunting for food, or solving environmental challenges. Additionally, exploring thoroughly and interacting with every available object or creature can yield hidden DNA points. In later stages, strategic use of parts and abilities can further boost your DNA collection, ensuring your creature evolves efficiently and unlocks its full potential.
Explore related products
What You'll Learn
- Complete Social Missions: Engage with other creatures to unlock rewards and earn DNA points
- Explore Planets: Discover new worlds, collect samples, and find hidden DNA bonuses
- Evolve Strategically: Upgrade traits efficiently to maximize DNA point gains in each stage
- Use Badges: Earn and equip badges that boost DNA points during gameplay
- Replay Stages: Revisit earlier levels to collect missed DNA points and resources

Complete Social Missions: Engage with other creatures to unlock rewards and earn DNA points
In the world of Spore, social interactions are not just about making friends; they're a strategic pathway to amassing DNA points. Completing social missions involves engaging with other creatures in meaningful ways, such as dancing, singing, or even posing for photos. These interactions not only foster alliances but also unlock rewards that directly contribute to your DNA point tally. For instance, successfully entertaining another creature might grant you access to a new part for your creature design, which in turn can be used to earn more DNA points through challenges or achievements.
To maximize your DNA point gains through social missions, it's essential to understand the nuances of each interaction type. Dancing, for example, requires rhythm and timing, while singing involves matching pitches. Creatures respond differently based on their temperament and species, so tailoring your approach can significantly impact your success rate. A creature that prefers aggressive displays might be more receptive to a dominant dance, whereas a peaceful species may appreciate a harmonious song. Experimenting with various social actions and observing creature reactions can help you refine your strategy.
One practical tip is to prioritize social missions during the Creature Stage, where interactions are most frequent and impactful. Focus on building relationships with creatures of higher social status, as they often offer more substantial rewards. Additionally, keep an eye on the mission log to track available social tasks and their corresponding DNA point rewards. Completing a series of social missions can sometimes unlock bonus DNA points or rare parts, so consistency is key.
While engaging in social missions, be mindful of potential risks. Misjudging a creature’s temperament can lead to conflicts, which may result in lost health or missed opportunities. Always assess the situation before initiating an interaction, and don’t hesitate to retreat if the creature shows signs of aggression. Balancing boldness with caution ensures that your social endeavors remain profitable.
In conclusion, mastering social missions in Spore is a dynamic way to earn DNA points while enriching your creature’s experience. By understanding the mechanics of each interaction, tailoring your approach, and staying vigilant, you can turn every encounter into an opportunity for growth. This method not only boosts your DNA point count but also adds depth to your gameplay, making it a rewarding strategy for both novice and experienced players alike.
Does Pasteurization Effectively Eliminate Bacterial Spores in Food Processing?
You may want to see also

Explore Planets: Discover new worlds, collect samples, and find hidden DNA bonuses
Exploring planets in Spore is a treasure hunt for DNA points, but not all worlds are created equal. Focus on T-scored planets, which are marked with a "T" on your galactic map. These planets are teeming with life and often contain multiple DNA bonuses hidden in their ecosystems. Prioritize visiting these worlds first, as they offer the highest concentration of rewards for your exploration efforts.
Once you land on a planet, collect samples of every unique organism and plant you encounter. Each sample grants a small amount of DNA, but the real payoff comes from discovering new species. Keep an eye out for glowing objects or anomalies in the environment—these often indicate hidden DNA bonuses. Use your scanner tool to highlight interactable items, ensuring you don’t miss any opportunities.
Hidden DNA bonuses are often tucked away in hard-to-reach areas or disguised as part of the terrain. Look for caves, cliffs, or unusual geological formations, as these are common hiding spots. Some bonuses require solving mini-puzzles, such as aligning symbols or activating switches, so be observant and patient. For example, on icy planets, melting frozen objects with your tool might reveal hidden DNA orbs.
A practical tip: upgrade your spaceship’s tools early in the game to maximize efficiency. The scanner’s range and the terrain manipulator’s power can significantly reduce the time spent searching for bonuses. Additionally, use the editor to create a creature with high jump or speed abilities, making it easier to access elevated or distant areas where DNA might be hidden.
Finally, don’t overlook satellite missions while exploring. Completing these side tasks, such as rescuing stranded creatures or repairing probes, often rewards you with DNA points. Combine these missions with your planet exploration to double your gains. By systematically exploring T-scored planets, collecting samples, and hunting for hidden bonuses, you’ll steadily accumulate DNA points while uncovering the wonders of the Spore galaxy.
When to Water After Applying Milky Spore for Optimal Results
You may want to see also

Evolve Strategically: Upgrade traits efficiently to maximize DNA point gains in each stage
In Spore, DNA points are the currency of evolution, and each stage presents a unique opportunity to maximize your gains. The key to success lies in understanding the value of traits and upgrading them strategically. Not all traits are created equal; some offer immediate benefits, while others provide long-term advantages. For instance, in the Cell Stage, investing in speed and health early on can help you outmaneuver predators and gather more food, leading to faster DNA accumulation. This principle of prioritizing high-impact traits applies across all stages, ensuring you get the most out of every point spent.
Consider the Creature Stage, where social interactions become crucial. Upgrading traits like charm and strength can significantly influence your tribe’s growth and survival. Charm allows you to ally with other creatures, reducing conflicts and increasing food supply, while strength ensures dominance in battles. However, balance is key—overinvesting in one trait at the expense of others can leave your creature vulnerable. For example, neglecting health upgrades while focusing solely on attack power might make you powerful but fragile. The goal is to create a well-rounded creature that thrives in its environment while efficiently gathering DNA points.
A comparative analysis of trait upgrades reveals that some stages require more tactical planning than others. In the Tribal Stage, for instance, tool-making and hunting skills are essential for resource acquisition. Upgrading these traits early can exponentially increase your tribe’s productivity, allowing you to progress faster. Conversely, the Civilization Stage demands a focus on vehicle upgrades and city expansion, as these directly impact your ability to conquer territories and earn DNA points. By analyzing each stage’s unique requirements, you can allocate points more effectively, avoiding the pitfall of generic upgrades that yield minimal returns.
To maximize DNA gains, adopt a step-by-step approach tailored to each stage. Start by identifying the core traits that align with your immediate goals—survival, resource gathering, or social dominance. Next, allocate points incrementally, ensuring each upgrade serves a clear purpose. For example, in the Space Stage, investing in spacecraft fuel efficiency and weapon upgrades can help you explore more planets and engage in profitable trade routes. Finally, regularly reassess your strategy as you progress, adapting to new challenges and opportunities. This methodical approach not only optimizes DNA accumulation but also enhances your overall gameplay experience.
Practical tips can further refine your strategic evolution. In the Cell Stage, focus on omnivorous diets to maximize food intake from both plants and meat. In the Creature Stage, experiment with different social interactions to discover which traits yield the highest DNA rewards. During the Tribal Stage, prioritize fire and farming upgrades to secure a stable food source. As you advance, keep an eye on the DNA point requirements for each trait, ensuring you’re not overspending on minor improvements. By combining these specific strategies with a broader understanding of each stage’s mechanics, you’ll evolve efficiently and dominate the game.
Understanding Trichoderma Spores' Lifespan: Survival Duration and Factors
You may want to see also
Explore related products

Use Badges: Earn and equip badges that boost DNA points during gameplay
Badges in Spore aren’t just flashy icons—they’re strategic tools for maximizing DNA points. Each badge you earn and equip can provide passive bonuses that directly or indirectly increase your DNA gains. For instance, the "Epicure" badge, earned by consuming 100 pieces of food, grants a permanent 5% increase to DNA points earned from eating. Similarly, the "Socialite" badge, awarded for making 100 friends, boosts DNA gains from socializing by 10%. These multipliers stack, meaning the more badges you equip, the greater your overall DNA accumulation.
Earning badges requires specific actions, so plan your gameplay to target badge-related achievements. For example, the "Explorer" badge, which increases DNA from discovering new areas, is earned by visiting 50 unique locations. Focus on exploration during the Creature or Tribal stages to unlock this badge early. Conversely, the "Carnivore" badge, which boosts DNA from hunting, requires 50 kills—ideal for players who prefer a predatory playstyle. Prioritize badges that align with your natural gameplay tendencies to maximize efficiency.
Equipping badges is just as crucial as earning them. In the Spore menu, navigate to the "Badges" section to select up to three active badges at a time. Strategically choose badges that complement your current stage and goals. For instance, during the Creature stage, equip the "Swimmer" badge (earned by swimming 100 meters) to boost DNA gains from aquatic activities. In the Tribal stage, the "Farmer" badge (earned by harvesting 50 plants) becomes invaluable for DNA-rich agriculture. Rotate badges as you progress to maintain optimal bonuses.
While badges are powerful, they’re not a one-size-fits-all solution. Some badges offer marginal benefits or require significant effort to unlock, making them less efficient for DNA farming. For example, the "Speedster" badge, earned by running 10 kilometers, provides only a 2% speed boost—useful for evasion but minimal for DNA gains. Instead, focus on badges with clear, high-impact bonuses like the "Omnivore" badge (10% DNA boost from eating plants and meat) or the "Builder" badge (15% DNA boost from constructing buildings in the Tribal stage). Prioritize quality over quantity to maximize your DNA yield.
In conclusion, badges are a dynamic system for enhancing DNA points in Spore, but their effectiveness depends on strategic earning and equipping. By targeting badges that align with your playstyle and stage objectives, you can create a synergistic boost to your DNA gains. Remember to regularly review your badge collection and adapt your choices as you progress through the game. With the right badges in play, you’ll find DNA points accumulating faster than ever, propelling your evolution to new heights.
Bryophytes and Meiosis: Understanding Their Spore Production Process
You may want to see also

Replay Stages: Revisit earlier levels to collect missed DNA points and resources
Replaying earlier stages in Spore is a strategic move to maximize your DNA points and resource collection. Unlike linear games where progression is strictly forward, Spore’s open-ended design allows you to revisit completed levels with upgraded abilities and tools. This mechanic transforms earlier stages from mere stepping stones into treasure troves of missed opportunities. Whether you overlooked hidden DNA strands or lacked the tools to access certain areas initially, replaying stages ensures you extract every possible point from the game.
To effectively replay stages, prioritize levels with high resource density or areas you rushed through during your first playthrough. For example, the Cell Stage often contains hard-to-reach DNA points in deep ocean trenches or behind obstacles. Returning with advanced creature abilities in the Creature Stage allows you to access these areas effortlessly. Similarly, the Tribal Stage’s hunting grounds may have hidden fruit or enemy tribes that offer additional DNA points when revisited with a stronger tribe. Keep a mental or written note of areas you suspect hold untapped resources to streamline your replaying efforts.
One cautionary note: avoid replaying stages too early in your progression. Returning to earlier levels before unlocking key abilities or tools can lead to frustration rather than efficiency. For instance, attempting to revisit the Cell Stage without the ability to glide or jump in the Creature Stage limits your exploration potential. Wait until you’ve unlocked significant upgrades to ensure each replay is maximally productive. This approach not only increases your DNA point yield but also enhances your overall gameplay experience by showcasing how your creature’s evolution has expanded its capabilities.
The takeaway is clear: replaying stages is not just a fallback strategy but a deliberate tactic to optimize your DNA point collection. By systematically revisiting levels with a critical eye and upgraded skills, you can turn overlooked areas into significant point gains. This method not only boosts your DNA points but also deepens your engagement with Spore’s intricate world, making it a win-win for both resource accumulation and immersive gameplay.
Can Shroom Spores Be Legally Delivered to California Residents?
You may want to see also
Frequently asked questions
DNA points in Spore are used to unlock new parts and abilities for your creature. You earn them by completing missions, exploring planets, and interacting with other creatures during the Creature Stage.
Yes, socializing with other creatures, hunting prey, and finding epic or rare objects on planets can yield higher DNA points. Completing quests from the monoliths also rewards significant amounts.
No, DNA points are exclusive to the Creature Stage. Once you progress to the Tribal Stage, you’ll earn other resources like Food, Tools, and Spice, but DNA points are no longer obtainable.

























